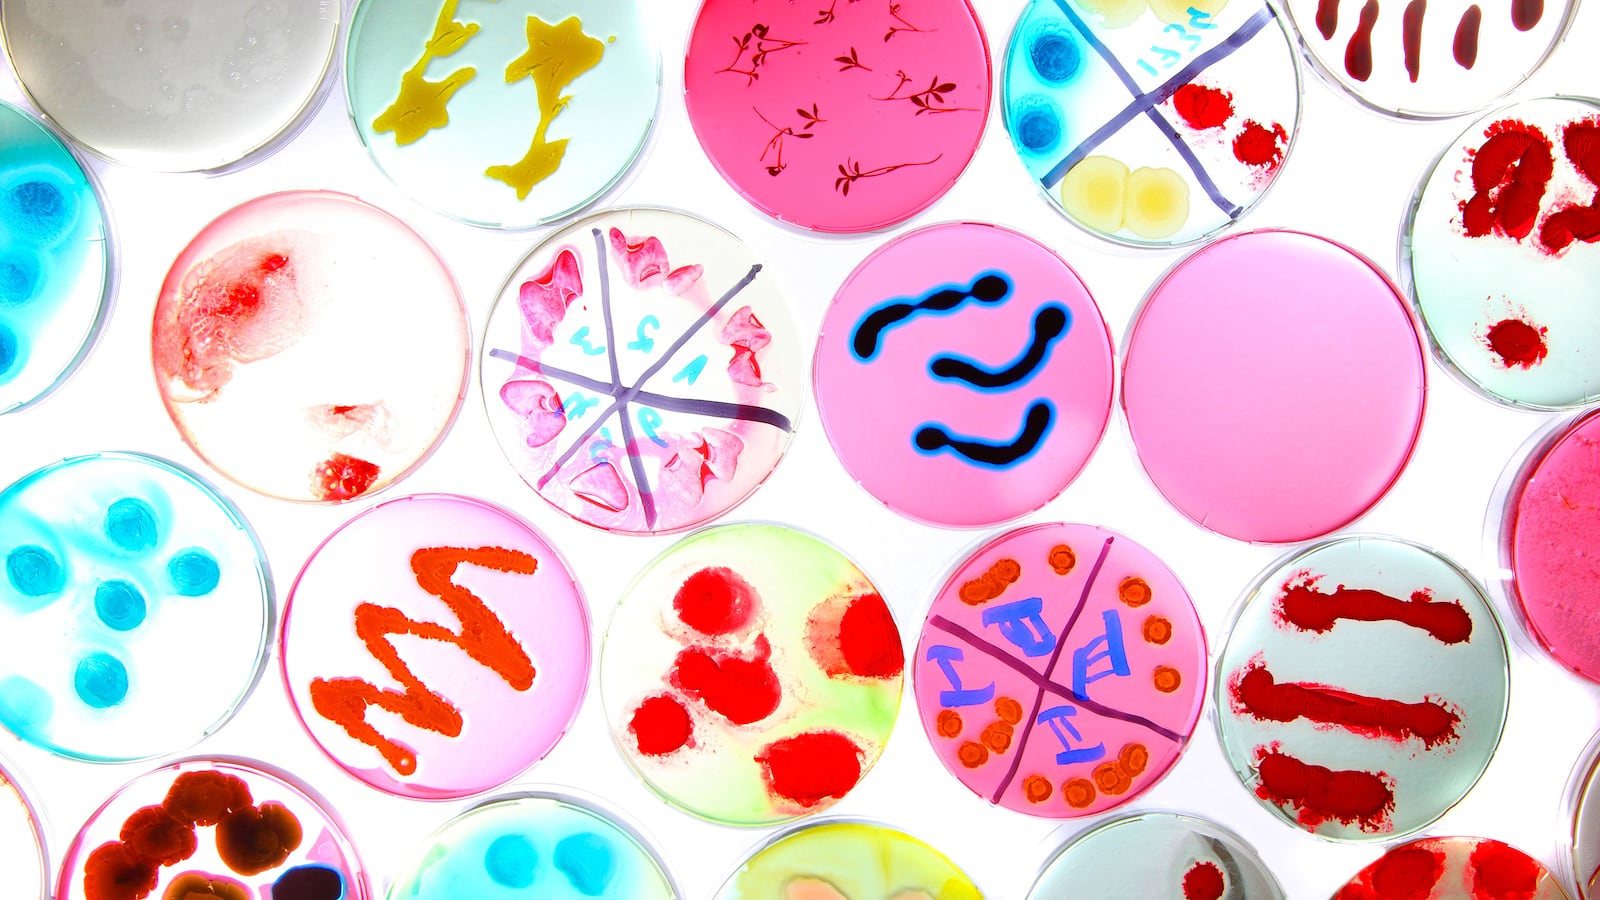
articles/2016/03/28/bacteria-s-achilles-heel-is-overblown/160327-sepkowitz-bacteria-tease_azo9yp

One thing we have learned this year is that Mother Nature sure has a lot of Achilles’ heels. Possibly.
Consider the evidence: Thus far in 2016, scientists have found an Achilles’ heel against cancer and, more recently, against drug resistant bacteria. Possibly.
Plus it’s only March. Imagine how many more Achilles’ heels we might identify by the end of the year. Maybe several. In every way, Achilles’ Heels ‘R’ Us!
Which brings up the question—what were all the goofball researchers doing for so many years when there were so many (possible) Achilles’ heels to find and exploit distributed throughout biology?
Consider cancer. A quick check on PubMed, which catalogues the hardcore medical literature, finds 303 entries for “Achilles’ heel cancer.” A related check on Google finds articles going back at least to 2001 when the “Achilles’ heel” for cancer first was trumpeted. (Actually I’m sure it goes much farther back than 2001, but I got tired of clicking.)
This particular 2001 heel derived from a Nobel-worthy insight into the possible role in cancer control of a protein called p53, which helps regulate genes that inhibit tumors. In the article, p53 (or its manipulation) was labeled a possible “Achilles’ Heel of cancer” and off we went into the world of our Myrmidon leader, Achilles, and his famous bit of anatomy.
Since then, binders full of Achilles’ heels have been turned up: cancer cell metabolism was an Achilles’ heel in 2008; a twist on cancer stem cells in 2010; the always-popular Eukaryotic initiation factor eIF2 in 2015; and of course 2016’s Heel of the Moment, the above work describing the possible utility of training our own immune systems to fight tumors. Or as the authors liltingly put it: “Clonal neoantigens elicit T cell immunoreactivity and sensitivity to immune checkpoint blockade.”
The Achilles’ heel brigade of cancer, by the way, is gender-fluid. Heels have been found against breast cancer and prostate cancer too. Plus, the prestigious Broad Institute has an entire Achilles’ Project aimed at probing cancer genes to identify weaknesses.
Not to be outdone, infections too are in the Heel chase. It is a natural fit—like cancer cells, bacteria, viruses, fungi, etc., are living things. So naturally they would have the same problem everything in nature seems to have—an Achilles’ heel. And sure enough, the ratta-tat-tat of Heel-dom is as loud in infectious disease as in cancer. OK, the National Library of Medicine PubMed count of articles is a tad lower—only 116 so far, but that’s just bacteria and their Heel problem.
For viruses there are handfuls more, including the Iliad-dizzying collision, “Dendritic cells as Achilles” heel and Trojan horse during varicella zoster virus infection” from just last year.
Through the past 15 years or so, infections have been thought to have a variety of Achilles’ heels, from this week’s suggestion that the acidity within the cell—or more exactly, the ability to maintain a certain acid-base balance—is heel-worthy. We also have seen Heels suggested by pathogens’ ability to evade detection, including for anthrax, as well as development of defensive barriers, to that odd bit of floating genetic material called a plasmid, to structural heels like the brick-and-mortar equivalents of the pathogen walls, and a birth-control-seeming configuration called the Z-ring relevant only to the notorious bacteria, MRSA.
Even the staid researchers of Old Europe from the Max Planck Institute are looking for Heel-power, albeit with a less-than-catchy approach that involves a bacterial protein called elongation factor P (EF-P).
Indeed, at times there seem to be more Achilles’ heels than infections to treat.
Which is fine actually. Excitement and enthusiasm and blind faith are not just fun but necessary. Every year, we have a new Willie Mays and a new Sandy Koufax, the latest Maria Callas, and of course the Saul Bellow for the Millennials. So why not let hope spring eternal in medicine as well?
The problem though is this: a fatal susceptibility to the concept of the Achilles’ heel in medicine and science. Looking at the last 100 years or so, there actually are very few clinically relevant steps forward based on discovery of an Achilles’ heel. Rather, progress is millimeter by millimeter measured by decades. No silver bullet or bouncing arrow or “wait, what if we just…” moments. And expecting to find an Achilles’ heel that will make all this bad stuff disappear is Disney, not science.
For the proper perspective on this issue, though, it makes sense to turn to Achilles himself, or at least his shade. In the 11th book of the Odyssey, Odysseus visits the Underworld and speaks to many now-dead heroes, including Achilles. On seeing him, Odysseus assures him he is just as famous as ever plus Numero Uno (more or less) in the Underworld—to which Achilles, he of the heel, only says:
“Glorious Odysseus: don’t try to reconcile me to my dying. I’d rather serve as another man’s labourer, as a poor peasant without land, and be alive on Earth, than be lord of all the lifeless dead.”
To my ear, Achilles is telling all those interested in finding the great and glorious heel, the headliner fix, the Nobel worthy grand-slam, the American Idol triumph, the winning Lotto ticket, to go back to work at the almost impossible task of daily living. Because only from there can real progress be made.